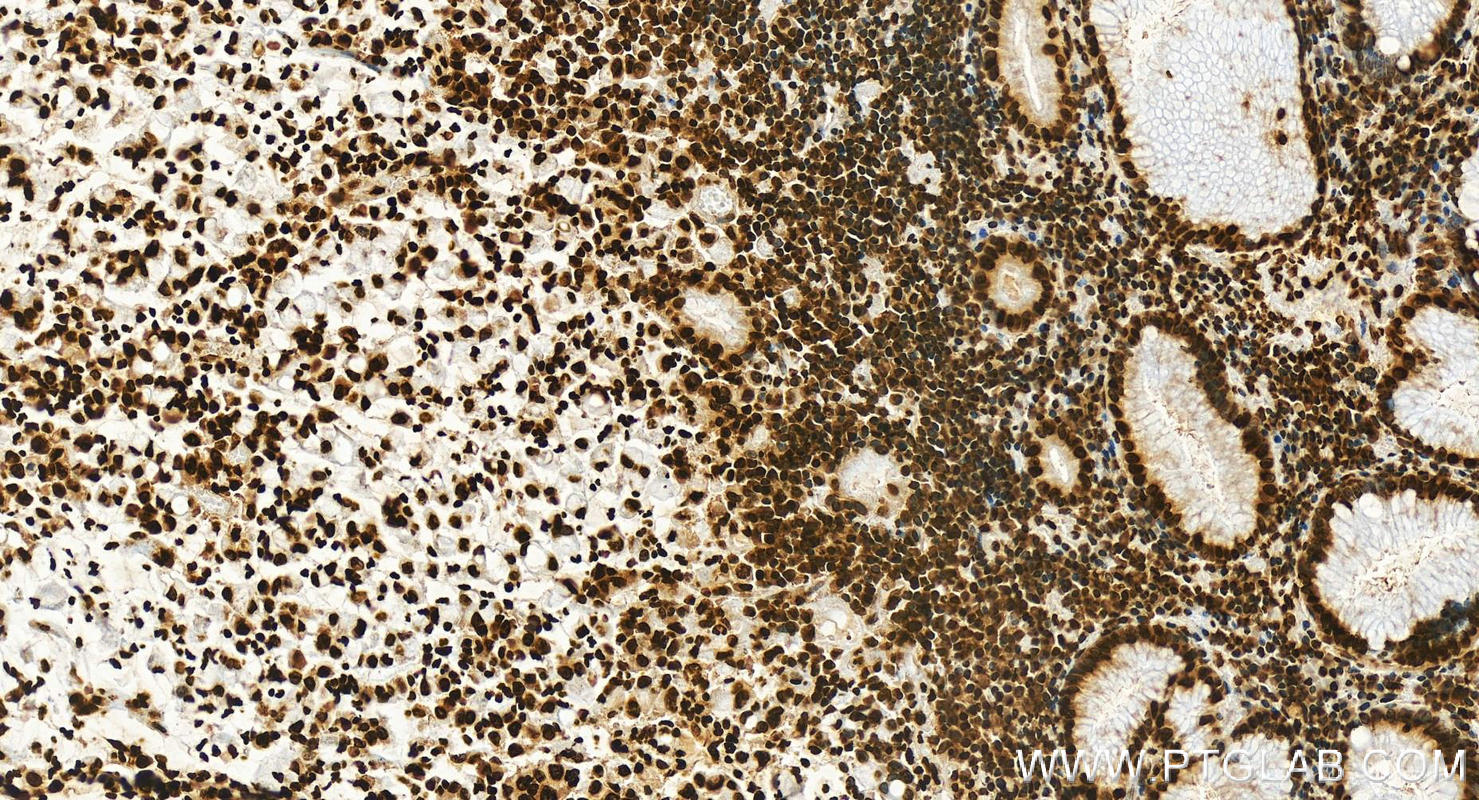

验证数据展示
产品信息
68888-1-PBS targets Histone H2A.X in WB, IHC, IF/ICC, FC (Intra), ELISA applications and shows reactivity with human, mouse, rat samples.
| 经测试应用 | WB, IHC, IF/ICC, FC (Intra), ELISA Application Description |
| 经测试反应性 | human, mouse, rat |
| 免疫原 |
Peptide 种属同源性预测 |
| 宿主/亚型 | Mouse / IgG1 |
| 抗体类别 | Monoclonal |
| 产品类型 | Antibody |
| 全称 | H2A histone family, member X |
| 别名 | H2AFX, 3E11B2, H2A histone family, member X, H2A.X, H2AX |
| 计算分子量 | 15 kDa |
| 观测分子量 | 17 kDa |
| GenBank蛋白编号 | BC013416 |
| 基因名称 | Histone H2A.X |
| Gene ID (NCBI) | 3014 |
| RRID | AB_3670446 |
| 偶联类型 | Unconjugated |
| 形式 | Liquid |
| 纯化方式 | Protein G purification |
| UNIPROT ID | P16104 |
| 储存缓冲液 | PBS only, pH 7.3. |
| 储存条件 | Store at -80°C. The product is shipped with ice packs. Upon receipt, store it immediately at -80°C |
背景介绍
Histone H2A.X belongs to the histone H2A family, which is synthesized in G1 and S phases. It is involved in nucleosomal organization of chromatin together with other histone proteins and is especially important for recombination between immunoglobulin switch regions. H2A.X becomes phosphorylated on serine 139 (to form gamma-H2AFX or H2AX139ph) in response to DNA double strand breaks (DSBs) generated by exogenous genotoxic agents and by stalled replication forks, which promotes DNA repair and maintains genomic stability. The calculated molecular weight of H2AX is 15 kDa, but the ubiquitinated H2A.X is about 22 kDa.